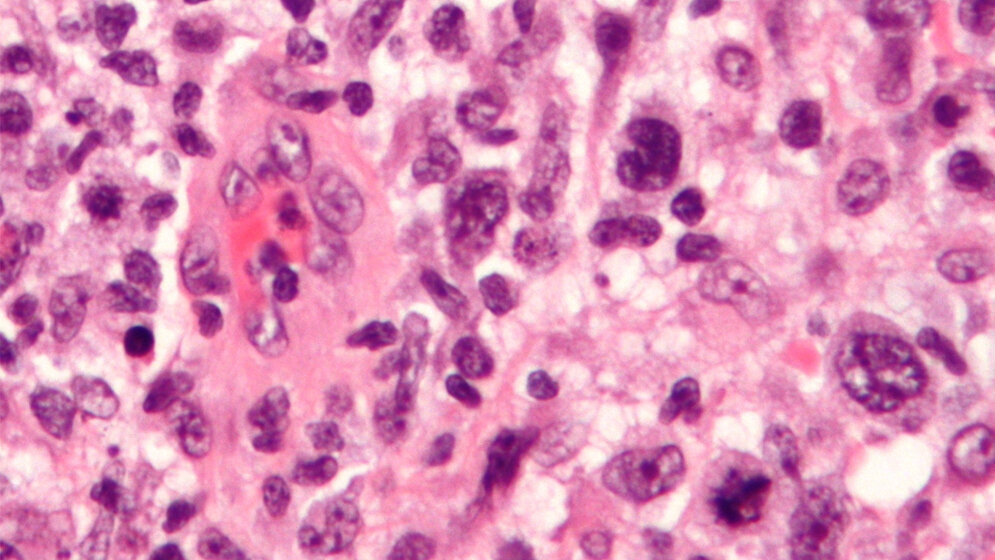
Histologisches Präparat eines ALCL in HE-Färbung

Ein Tumorprotein steht im Fokus des von der Europäischen Union (EU) geförderten Projekts „ALKATRAS: Break free from Cancer“. Im Rahmen dieses aus 13 Forschergruppen bestehenden „Marie Curie Innovative Training Networks“ (ITN) werden neue Strategien gegen Krebsarten gesucht, die von dem Tumorprotein anaplastische Lymphomkinase (ALK) abhängen. Gießener Wissenschaftlerinnen und Wissenschaftler beschäftigen sich in ihrem Teilprojekt mit ALK-getriebenen Lymphknotenkrebserkrankungen bei Kindern und Jugendlichen und konnten hier bereits erste Erfolge erzielen.
Derzeit nur 70 Prozent heilbar
Im Gegensatz zu anderen Lymphknotenkrebserkrankungen bei Kindern können derzeit nur 70 Prozent der Kinder mit ALK-positiven Lymphomen – Krebsarten, bei denen weiße Blutkörperchen des Immunsystems entartet sind – durch eine intensive Chemotherapie geheilt werden. Die Forschergruppe von Prof. Dr. Wilhelm Wößmann und Dr. Christine Damm-Welk in der von Prof. Dr. Dieter Körholz geleiteten Kinderonkologie erforscht die Immunantwort gegen diese ALK-positiven Lymphome. Die Wissenschaftlerinnen und Wissenschaftler konnten bereits nachweisen, dass Kinder mit einer starken Antikörperreaktion gegen das ALK-Protein ein geringes Rückfallrisiko haben. Nun wollen sie spezifische Immunzellen gegen das Tumorprotein ALK bei Kindern untersuchen.
CD4-Lymphozyten-Reaktionen gegen ALK
Erste Ergebnisse zeigen, dass Kinder mit ALK-Lymphomen eine zellbasierte Immunabwehr gegen das Tumorprotein ausbilden. Bei der Immunabwehr gegen Krebszellen spielen die sogenannten CD4-Helferlymphozyten eine wichtige Rolle. Für die Erforschung dieser Immunantwort konnte im Rahmen des EU-Projektes Serena Stadler als Marie-Curie-Fellow gewonnen werden. Die Biologin mit Masterabschluss aus Wien untersucht in ihrer Doktorarbeit in Gießen die CD4-Lymphozyten-Reaktionen gegen ALK. Die Charakterisierung dieser ALK-Immunzellen bildet die Grundlage für das Fernziel der Forschergruppe, eine Impfstrategie gegen das ALK-Protein zur Tumorbehandlung zu entwickeln. Eine solche Impfung könnte einen Teil der Chemotherapie ersetzen und einen Rückfall der Erkrankung verhindern, indem das Abwehrsystem der betroffenen Kinder spezifisch gestärkt wird, den Lymphknotenkrebs zu bekämpfen.
Serena Stadler hat in den ersten Monaten ihrer Arbeit in Gießen bereits Methoden zur Messung der Lymphozytenantwort gegen ALK etablieren können. Der Austausch mit den anderen 14 Doktorandinnen und Doktoranden des EU-Programms zu ALK-abhängigen Tumoren ermöglicht ein tiefes Verständnis über das Zielprotein ALK. Die jungen Wissenschaftlerinnen und Wissenschaftler erhalten dabei auch Einblicke in die industrielle Biotechnologie, stärken ihre Fähigkeiten im interkulturellen Umgang sowie bei der Vermittlung ihrer Forschung.
„Innovative Training Networks“
„Innovative Training Networks“ (ITN) sind europäische Netzwerke von Einrichtungen zur strukturierten Ausbildung des wissenschaftlichen Nachwuchses. Ziel dieser EU-finanzierten Graduiertenkollegs ist die Erweiterung der wissenschaftlichen und allgemeinen Kompetenzen der Mitglieder innerhalb eines internationalen, interdisziplinären und intersektoralen Forschungs- und Ausbildungsprogramms.
Marie-Skłodowska-Curie-Maßnahmen (MSCA), zu denen die „Innovative Training Networks“ gehören, wurden von der Europäischen Kommission eingerichtet, um die länder- und sektorübergreifende Mobilität und die Karriereentwicklung von Forscherinnen und Forschern zu fördern und die Attraktivität von wissenschaftlichen Laufbahnen zu steigern. Seit 2014 werden die MSCA-Maßnahmen über das Rahmenprogramm für Forschung und Innovation „Horizont 2020“ finanziert. (idw, red)
Weitere Informationen zum Projekt gibt es hier.
Artikel teilen